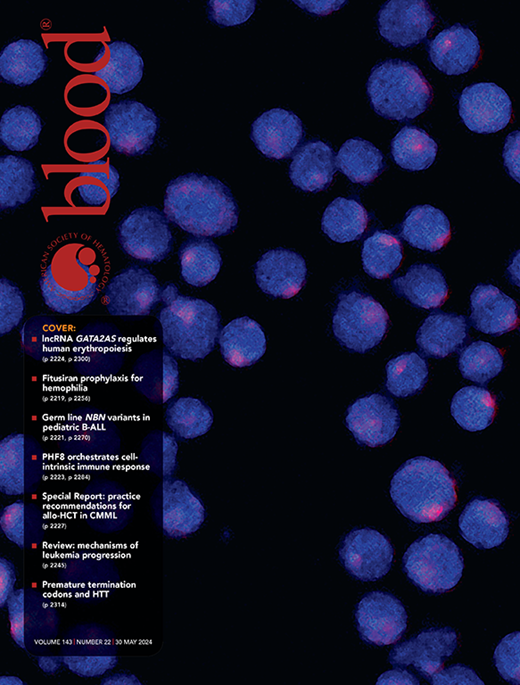

In this issue of Blood, Liu et al report acceleration of erythroid differentiation and reduction of fetal hemoglobin expression after depletion of a GATA2 gene-associated antisense long noncoding RNA.1
Transcription factor GATA2 plays an important role in the maintenance of hematopoietic stem cells and in the specification of hematopoietic cell lineages derived from common myeloid progenitors.2 During maturation of erythroid cells, expression of GATA2 is gradually downregulated and expression of GATA1 increases, leading to the replacement of GATA2 by GATA1 at specific genomic sites, known as GATA switch sites.3 Mutations in GATA2 cause GATA2 deficiency syndrome, characterized by bone marrow failure, cytopenia, and increased risk of myeloid malignancies.2 Previous studies have implicated a long noncoding GATA2 gene-associated antisense transcript (GATA2AS) in the regulation of GATA2.4,5
The authors used CRISPR/Cas9 or short hairpin RNA (shRNA) to deplete GATA2AS in HUDEP2 or differentiating primary human erythroid cells, respectively. The results show that GATA2AS deficiency reduced proliferation and increased expression of erythroid differentiation markers. Both GATA2 and GATA1 expression was reduced in GATA2AS-deficient cells. Many differential chromatin-accessible sites in the GATA2AS-depleted cells represent GATA factor switch sites. Chromatin association studies revealed that GATA2AS occupies thousands of genomic regions and interacts with cis-regulatory elements of erythroid-specific genes bound by transcription factors LRF and KLF1. RNA immunoprecipitation experiments identified LRF and KLF1 as GATA2AS interacting proteins. Interestingly, depletion of GATA2AS reduced LRF and KLF occupancy at erythroid promoters and enhancers. Although adult globin genes were slightly upregulated in GATA2AS-deficient cells, there was a strong reduction in expression of the fetal γ-globin genes as well as in the number of F cells.
The authors show that GATA2 is regulated by the GATA2AS long noncoding RNA (lncRNA) rather than by the cis-regulatory elements driving GATA2AS expression. This is substantiated by the fact that shRNA-mediated depletion of GATA2AS in primary erythroid cells reduced GATA2 messenger RNA (mRNA). The data are consistent with previous findings showing that GATA2AS recruits the DEAD-box helicase DDX3X, which stabilizes GATA2 mRNA.4 Thus, the effect on cell proliferation and erythroid cell differentiation upon GATA2AS depletion is likely caused by a combination of reduced GATA2 expression and a direct effect of the GATA2AS lncRNA on the expression of LRF- and KLF1-regulated erythroid-specific genes (see figure). Perhaps surprisingly, a previous study identified a 187-kilobase duplication of the GATA2 gene locus in a patient with GATA2 deficiency syndrome.5 The GATA2 locus duplication was associated with a decrease in GATA2 and a strong increase in GATA2AS expression. It is possible that the duplication alters long range cis-regulatory interaction patterns in the GATA2 gene locus. However, the findings also suggest that relatively precise GATA2AS expression levels are critical for its regulatory function during erythropoiesis.
Liu et al show that a GATA2-associated antisense RNA (GATA2AS) positively regulates GATA2 mRNA and interacts with transcription factors LRF and KLF1 at regulatory DNA elements in promoters of erythroid-specific genes. Depletion of GATA2AS in erythroid progenitor cells causes a reduction of proliferation, an upregulation of erythroid marker genes, and a decrease in fetal hemoglobin.
Liu et al show that a GATA2-associated antisense RNA (GATA2AS) positively regulates GATA2 mRNA and interacts with transcription factors LRF and KLF1 at regulatory DNA elements in promoters of erythroid-specific genes. Depletion of GATA2AS in erythroid progenitor cells causes a reduction of proliferation, an upregulation of erythroid marker genes, and a decrease in fetal hemoglobin.
The implication of GATA2AS in the regulation of fetal hemoglobin is particularly important with respect to β-hemoglobinopathies. Activation of fetal hemoglobin by hydroxyurea (HU) and histone deacetylase (HDAC) inhibitors correlates with increased GATA2 expression.6,7 Thus, the decrease in fetal hemoglobin in GATA2AS-deleted cells may in part be due to a decrease in GATA2, and it would be interesting to examine if GATA2AS expression increases in response to HU or HDAC inhibitors. The data by Liu et al suggest an additional mechanism by which GATA2AS regulates fetal hemoglobin. Both LRF and KLF1 suppress expression of γ-globin, either directly through interactions with the promoter regions or through activation of BCL11A.8,9 Neither LRF, KLF1, nor BCL11A expression levels change upon GATA2AS depletion, suggesting that the positive role of GATA2AS on γ-globin expression is mediated by sequestration of LRF and perhaps KLF1. Alternatively, depletion of GATA2AS reduces occupancy of LRF and KLF1 at co-occupied sites, thus increasing the available pool of these proteins for other processes including fetal globin gene repression.
The authors provide compelling evidence for direct or indirect interactions of LRF and KLF1 with GATA2AS. This includes RNA pull-down, colocalization of GATA2AS at LRF/KLF1-occupied loci, and reduction of LRF/KLF1 chromatin interactions in GATA2AS-depleted cells. Previous findings on interactions of transcription factors and coregulators with lncRNA have recently been challenged by Guo et al,10 who used a novel procedure involving denaturing purification of in vivo cross-linked RNA-protein complexes. Future studies may involve a more detailed analysis of the nature, specificity, and stability of LRF/KLF1/GATA2AS RNA-protein complexes.
In summary, the study by Liu et al demonstrates that GATA2 sense and antisense RNAs are important regulators of erythroid progenitor cell proliferation and differentiation.
Conflict-of-interest disclosure: The authors declare no competing financial interests.